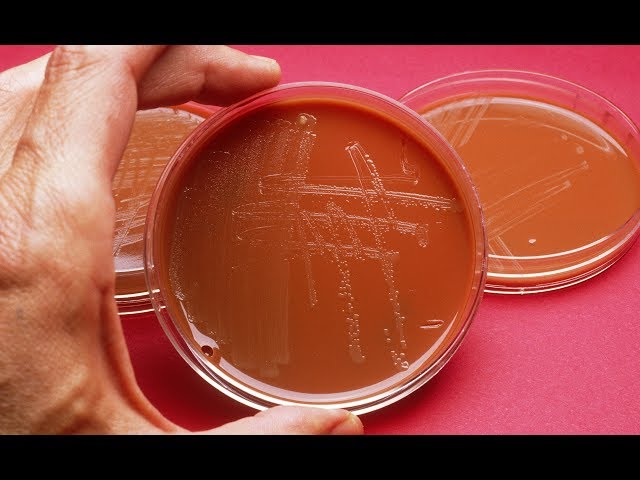

Channel / Source:
The David Pakman Show
Published: 2017-07-14
Source: https://www.youtube.com/watch?v=SK5GayRG8B4